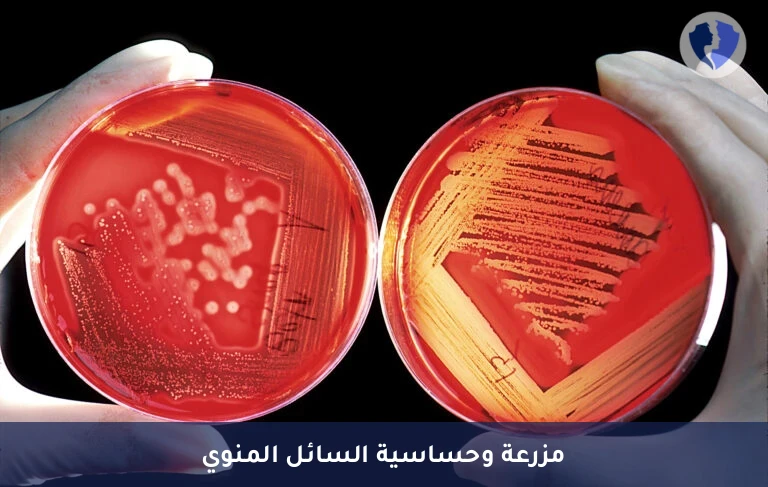
مزرعة سائل منوي دقيقة - مزرعة وحساسية السائل المنوي

تفاصيل الخدمة
مزرعة سائل منوي دقيقة - مزرعة وحساسية السائل المنوي
فحص يشمل الزراعة (Culture) لعينة السائل المنوي (المني) على أوساط مغذية خاصة للكشف عن وجود وعدد مستعمرات البكتيريا أو الكائنات الدقيقة الأخرى. إذا تم عزل ميكروب، يُتبع ذلك اختبار الحساسية للمضادات الحيوية (Antibiotic Susceptibility Testing) لتحديد أنسب مضاد حيوي للعلاق. يُستخدم للكشف عن عدوى الغدة المنوية، البربخ، أو البروستاتا التي قد تؤثر على السائل المنوي.